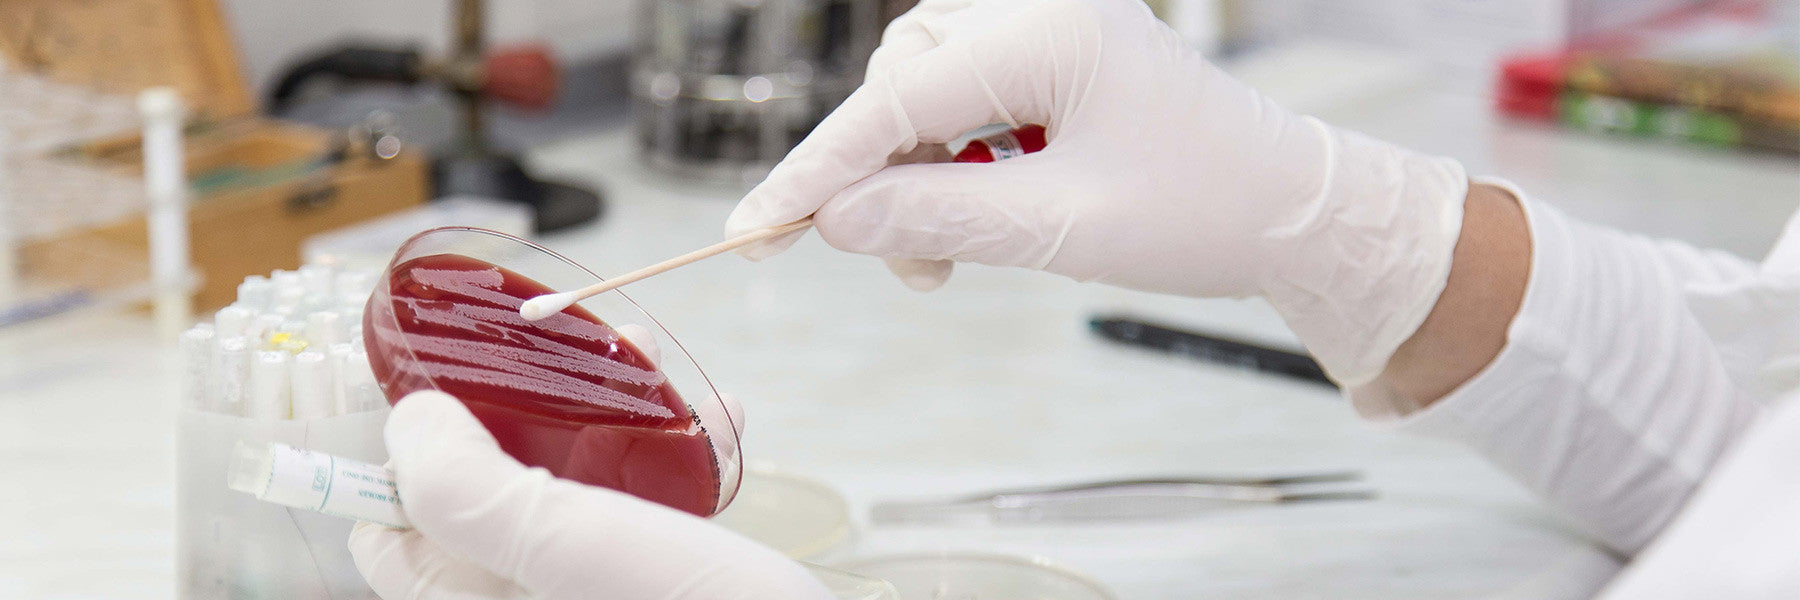
Company Profile

PMT(GB) LTD
Company Profile
Company Profile
PMT (GB) Ltd is an ISO 9001:2015 quality led company with ISO17025 Accreditation (0829) for Particle Counter Calibrations and Air Samplers.
We are dedicated to the provision and service of Particle Counters, Facility Monitoring Systems, Microbial Air Samplers, Rapid Microbial Detection Instruments and Ionisation equipment.
PMT (GB) Ltd is a member of a group of independent companies operating throughout France, Belgium, Netherlands, Ireland, Switzerland and Germany, all dedicated to contamination control within critically controlled industries, and all working together to provide total European expertise and support.
Our core areas of expertise are primarily focused on the following industry sectors:
-
Pharmaceutical
-
Healthcare
-
Electronics
-
Telecommunications
-
Automotive
-
Environmental
-
Research
-
Life Science
-
Stem Cell
-
Biomedical
To visit our corporate website click here